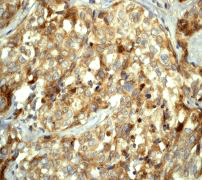

> Antigen, Antibodies, ELISA, Western Blot > Primary Antibody > Monoclonal Antibodies > MAPILC3A Antibody (C-term)Brand |
Leading Biology | Catalog Number |
APR08344G |
Product Type |
Monoclonal Antibodies | Field of Research |
|
Product Overview |
We constantly strive to ensure we provide our customers with the best antibodies. As a result of this work we offer this antibody in purified format.
We are in the process of updating our datasheets. If you have any questions regarding this update, please feel free to contact our technical support team.
This product is a high quality MAPILC3A antibody (C-term).
|
||
Molecular Weight |
14272 Da
|
||
Cellular Localization |
Antigen Cellular Localization:
Cytoplasm, cytoskeleton. Endomembrane system; Lipid-anchor. Cytoplasmic vesicle, autophagosome membrane; Lipid-anchor. Note=LC3-II binds to the autophagic membranes
|
||
Host |
Rabbit
|
||
Species Reactivity |
Human, Mouse, Rat
|
||
Target |
A synthetic peptide corresponding to residues on the C-terminus of human MAPILC3A was used as an immunogen.
|
||
Clone |
EP1983Y
|
||
GeneID |
|||
UniProt ID |
|||
Function |
Ubiquitin-like modifier involved in formation of autophagosomal vacuoles (autophagosomes). Whereas LC3s are involved in elongation of the phagophore membrane, the GABARAP/GATE-16 subfamily is essential for a later stage in autophagosome maturation.
|
||
Summary |
Microtubule-associated MAPILC3A constitute nearly half of the mass of all the microtubule associated proteins that copurify with brain microtubules. MAPILC3A is composed of a heavy chain and multiple light-chain subunits. Amino acid sequencing of a 120 kd microtubule-binding and light chain-binding fragment of the heavy chain reveals that light chain 1 binds near the heavy chain N-terminus. These data indicate that the heavy chain and light chain 1 are produced by proteolytic processing of a MAP1B polyprotein and form a complex microtubule-binding domain (1). There are three human orthologs of the rat Map1LC3, named MAP1LC3A, MAP1LC3B, and MAP1LC3C. The three isoforms of human MAP1LC3 exhibit distinct expression patterns in different human tissues and also differ in their post-translation modifications. MAP1LC3A and MAP1LC3C are produced by the proteolytic cleavage after the conserved C-terminal Gly residue; MAP1LC3B does not undergo C-terminal cleavage and exists in a single modified form (2).
|
||
Form |
50 mM Tris-Glycine (pH 7.4), 0.15 M NaCl, 40% Glycerol, 0.01% sodium azide and 0.05% BSA. |
||
Storage & Stability |
Store at +4°C short term. For long-term storage, aliquot and store at -20°C or below. Stable for 12 months at -20°C. Avoid repeated freeze-thaw cycles.
|
||
Applications |
WB, IHC
|
||
Dilution |
WB~~1:10000
IHC~~1:100~250
|
||
Synonyms |
Microtubule-associated proteins 1A/1B light chain 3A, Autophagy-related protein LC3 A, Autophagy-related ubiquitin-like modifier LC3 A, MAP1 light chain 3-like protein 1, MAP1A/MAP1B light chain 3 A, MAP1A/MAP1B LC3 A, Microtubule-associated protein 1 light chain 3 alpha, MAP1LC3A
|
||
Images |

A. Western blot analysis on HeLa cell lysate using anti-MAPILC3A RabMAb (Cat. APR08344G).
B. Immunohistochemical staining of paraffin-embedded human breast carcinoma using anti-MAPILC3A RabMAb (Cat. APR08344G). |
||
Specification |
|||
Quantity |
|
||
| Select | Brand | Catalog No. | Product Name | Pack Size | Type | Field of Research | Specification | Quantity | Price(USD) | |
| 1 | Leading Biology | APG02467G | CCK4 / PTK7 Antibody (clone 4F9) | 50 μl | Monoclonal Antibodies |
|
$495.00 | Add Ask | ||
| 2 | Leading Biology | AMM04683G | GALT Antibody (clone 4C11) | 50 μg | Monoclonal Antibodies |
|
$545.00 | Add Ask | ||
| 3 | Leading Biology | AMM01402G | Vimentin (Mesenchymal Cell Marker) Antibody - With BSA and Azide | 50 ug | Monoclonal Antibodies |
|
$395.00 | Add Ask | ||
| 4 | Leading Biology | APR08280G | LTA4H / LTA4 Antibody (clone 9G8) | 50 μl | Monoclonal Antibodies |
|
$495.00 | Add Ask | ||
| 5 | Leading Biology | AMM00172G | CD1a / HTA1 (Mature Langerhans Cells Marker) Antibody - With BSA and Azide | 50 ug | Monoclonal Antibodies |
|
$395.00 | Add Ask | ||
| 6 | Leading Biology | AMM05750G | CEBPA Antibody | 100 μl | Monoclonal Antibodies |
|
$545.00 | Add Ask |
 Leading Biology Inc.
2600 Hilltop DR, Building G, B Suite C138
Richmond, CA, 94806
Tel: 1-661-524(LBI)-0262
Email: info@leadingbiology.com
Leading Biology Inc.
2600 Hilltop DR, Building G, B Suite C138
Richmond, CA, 94806
Tel: 1-661-524(LBI)-0262
Email: info@leadingbiology.com
Complete this form and click send to ask us a question, request a quote or simply say hello.

You have 0 item in your cart

You have 0 item in your inquiry list
